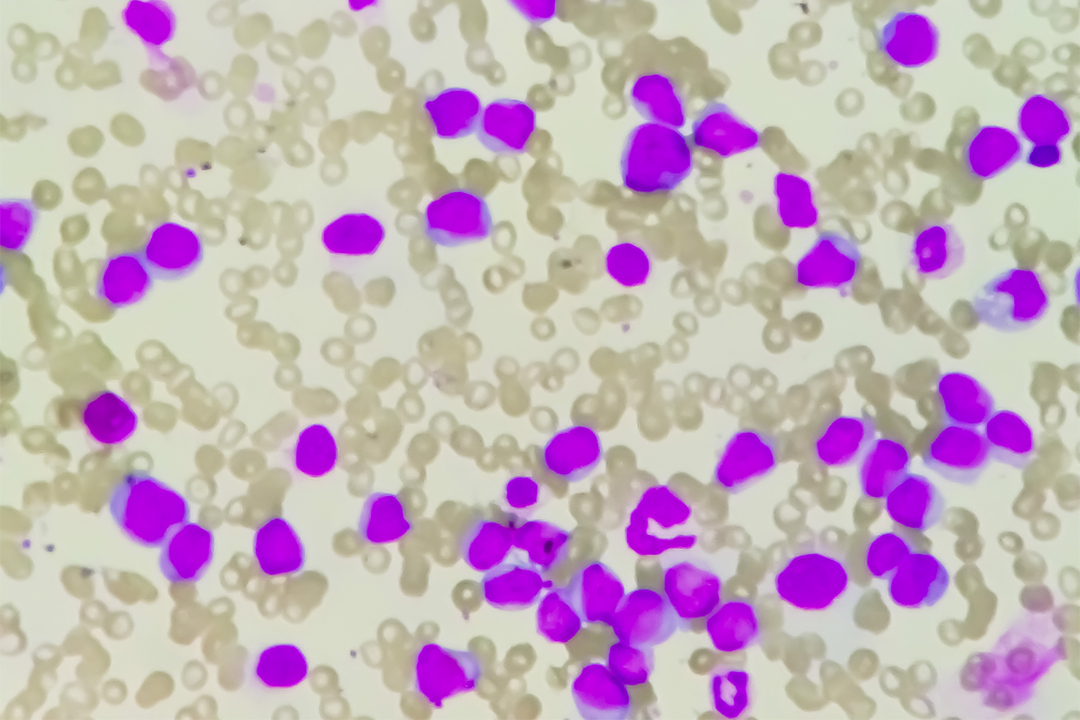
alt

Hämatoonkologie
Gemeinsam die Grenzen der Krebsbehandlung verschieben!
Mit innovativen und effektiven Therapien möchten wir krebskranken Menschen ein besseres und längeres Leben ermöglichen. Dafür sind wir seit mehr als zehn Jahren in der onkologischen Forschung und Arzneimittelentwicklung aktiv.
Herzlich willkommen!
Im Therapiebereich Hämatoonkologie entwickelt AbbVie Innovationen, um damit das Leben von betroffenen Menschen zum Besseren zu verändern. Hier haben wir sowohl für medizinische Fachkreise, aber auch für Patient*innen und Angehörige umfassende Informationen zusammengestellt. Sie erhalten einen Einblick in unser Engagement im Bereich der Hämatoonkologie, aber vor allem auch praxisrelevante Informationen und Services zur Unterstützung im Umgang mit der chronischen lymphatischen Leukämie (CLL) sowie der akuten myeloischen Leukämie (AML).
Sie suchen nach detaillierten Informationen für Patient*innen?
Quellen
AT-VNCLY-230027-02072025